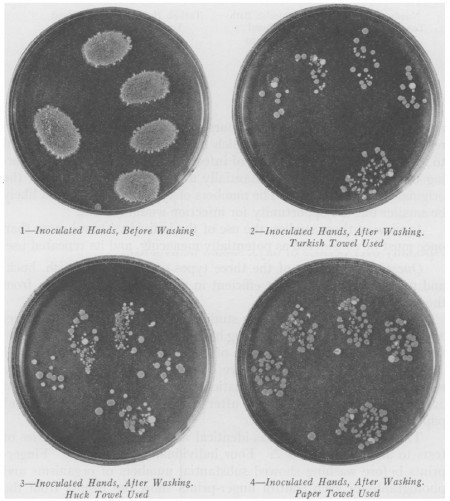

Marc Abrahams's Blog, page 416
March 24, 2014
Marcus Byrne explains how dung beetles use the Milky Way
Ig Nobel Prize winner Marcus Byrne explains how dung beetles use the Milky Way, navigationally, to find its way home:
(Thanks to Steve Ting for bringing this to our attention.)

March 23, 2014
The curious true tale of the the Swedish prime minister, a Soviet submarine, and farting herring
Professor Magnus Whalberg took part, many years ago, in an odd historic passage that involved the Swedish prime minister (Carl Bildt), a Soviet submarine, and farting herring. Years after the event, in 2004, Whalberg and his colleague Håkan Westerberg were awarded an Ig Nobel Prize — though the Ig Nobel Board of Governors was at the time completely unaware of the part of the story involving the prime minister and the submarine (the prize was awarded purely for the herring research, and was shared with a Canadian/Scottish research group that had independently, and with very different motivation, performed similar herring research).
This video shows Professor Whalberg’s TEDx Gothenberg Talk in 2012, in which he tells all (or at least much). It includes a snippet of film that Whalberg and Westerberg originally made, under great secrecy, for the Swedish military:

March 22, 2014
The effect of centrifugal birthing on an art critic
Rachel Lavin writes in The University Times, about Science Gallery [Dublin]‘s “Fail Better” exhibition:
Some of the highlights are Christopher Reeve’s wheelchair, Samuel Beckett’s original manuscript drafts of Westward Ho, and most intriguingly, a human birthing machine that earned itself an Ig Nobel Prize. The machine has been rebuilt for viewing and is available to stare at in utter disbelief at in the exhibition. It was originally intended to help women deliver babies through centrifugal force. For all you non-physics students, this basically involved strapping the woman to a bed and spinning her until the baby popped out, into a somewhat inadequate net that resembles a small goal. This is a must-see…

The fall and rise of lefties in Victorian England
In this 1997 interview, Ed Yong asked Ig Nobel Prize winner Chris McManus about “The fall and rise of lefties in Victorian England“.
McManus was awarded the 2003 Ig Nobel Prize for medicine, for his excruciatingly balanced report, “Scrotal Asymmetry in Man and in Ancient Sculpture.” [PUBLISHED IN: Nature, vol. 259, February 5, 1976, p. 426.]

March 21, 2014
‘Pigness’ (Cinematic and Televisual) – a thesis
One of academia’s most prominent accounts of ‘Pigness’ in motion pictures was authored in 2010 by Dr. Mark von Schlemmer (University of Central Missouri, Department of Communication and Sociology) in partial fulfillment of the requirements for the degree of Doctor of Philosophy, With reference not only to leading examples of cinematic pigs (like Babe and Hamm) but also TV pigs (Piggley Winks and Professor Strangepork).
The paper :
“… explores how these works invite spectators to construct nonhuman beings as persons and how they present nonhuman perspectives, and then it interrogates the accuracy of the pigness of the characters depicted.”
And goes on to show :
“The emotional connection which these fictive depictions generate in the discourse surrounding motion picture pigs is accessible and relatable, and, as this study has shown, often consists of elements of authentic pigness that can engender understanding and compassion on the part of humans who have not had the privilege to encounter pigs in their own actual lives.”
The 239 page thesis can be read in full here : ‘Cinematic “Pigness”: A Discourse Analysis of Pigs in Motion Pictures.’
BONUS (video cited in the paper, as is the commercial above.) ‘Pig Pens & Tiaras’ featuring the Ohio Pork Queen, 2008

March 20, 2014
Ig Nobel tour of Denmark and Sweden
Join us at one (or more than one, if you like and can) of the Ig Nobel events in Denmark and Sweden:
DENMARK (Special thanks to Carlsbergs Mindelegat for supporting this tour!) —
Monday, March 24: AARHUS: University of Aarhus. [Book TICKETS]
Tuesday, March 25: AARHUS. [Book TICKETS]
Wednesday, March 26: COPENHAGEN, Copenhagen University, Festsalen, Frue Plads 4, 1168, 7:00 pm. [Book TICKETS]
SWEDEN—two shows in STOCKHOLM on the same day, Thursday, March 27:
Karolinska Institute, Thursday, March 27, 3:30 pm
ABF House , Sveavägen 41, Thursday, March 27, 6:30 pm.
All these events feature Marc Abrahams, and these Ig Nobel Prize winners who will explain and perhaps demonstrate their prize-winning achievements:
Brian Crandall (who conducted the experimental swallowing and excreting of a parboiled shrew)
Masanori Niimi (who probed the effect of listening to opera, on heart transplant patients who are mice)
Kees Moeliker (who documented homosexual necrophilia in the mallard duck, and who will now tell the strange recent history of pubic lice)
BONUS: FULL SCHEDULE of Improbable events.

Trading typhoid with your towels
We’ve probably all wondered, when drying our hands… this is supposedly a net transfer of germs from us to the towel, but at what point does the towel become so filth-riddled that we are now transferring germs from the towel to us?
An early investigation of this was done in the American Journal of Public Health (August 1930: vol. 20, no. 8, pp. 820-832) by Herbert Pease and Lester Himebaugh of the Pease Laboratories (previously Lederle Laboratories, before Herbert Pease came along). They used ingenious methods including multiple types of towels (“Huck”, “Turkish”, and paper) and bacteria of three distinct colors: Flavobacterium lutescens for yellow, Bacillus prodigiosus (now called Serratia marcescens) for red, and Micrococcus aureus (now called Staphylococcus) for golden orange.
Their results were altogether dispiriting and distressing. In brief: bacteria don’t die on towels; they are as easily transmitted between people via towel than by direct human-to-human contact; and you can’t cheap out on towels, because the high-quality Turkish ones clearly remove the most bacteria from the skin. The quantitative towel hygiene field seems to have made no advances for decades thereafter, as investigators were too depressed by what they might find.
Follow Amboceptor on Twitter: @AmboceptorBlog
Sample fingerprints from Pease and Himebaugh (1930)

March 19, 2014
Holes in donuts – the philosophical implications (part 2)
In 2001, professor Achille C. Varzi, of Columbia University, New York, very probably became the first philosopher to author a paper focusing specifically on the ramifications of holes in donuts (that’s ‘doughnuts’ in the UK), as we reported. But the paper wasn’t, in the literal sense, the last word on donut holes. In 2012 the subject received further attention, this time from professor Stephen Barker and Mark Jago at the philosophy department at the University of Nottingham, UK. Their paper ‘Being Positive About Negative Facts’. (in: Philosophy and Phenomenological Research,85 (1):117-138) has a section partially devoted to donuts. (7, Constitution and Holes, page 12) in which they point out that :
“Donuts are material objects. The thing about donuts, however, is that they have holes. If you get rid of the donut hole by filling it up with more donut-dough, then there is no longer a donut.”
“Holes pose something of a philosophical quandary and, perhaps as a result of their mystery, are often treated as immaterial entities (Casati and Varzi 1994). Yet we seem to be able to perceive holes, gaps, dents and the like. The view of holes as immaterial objects is, we think, very much in line with thinking of the negative as the metaphysically undead. Given our acceptance of negative facts, we can offer a story about holes on which they are material entities. If there is a donut hole then there is a spatial region involving the instantiation of donut-dough which is intimately connected with an absence thereof.”
Improbable will of course endeavour to keep readers informed about future donut-centred philosophical investigations, should any arise to our attention.
Note on spelling : Curiously, although the authors are based at a UK university, they use the American spelling ‘donut’ throughout the paper – whereas professor Varzi, who’s at Columbia University in New York, goes exclusively for the English spelling, ‘doughnut’.
Luscious donut photos are kindly provided by photographer Evan Amos.

Ig Nobel occurrence at Leeds on Thursday night
Join us Thursday evening, March 20, at 7:00, at the University of Leeds for the Ig Nobel Prize show. The show features, among other things: Marc Abrahams / Dave Schults, Iwho will present his research as to whether it rains more often on weekends, and some Dramatic Improbable Readings from bizarre, genuine studies .
One can (and perhaps should?) book TICKETS, as seating is strictly limited to the interior of the building (the Conference Auditorium). No seats will be permitted on the building’s roof, in the sub-basement, in the grassy and/or concrete surround. No person older than 97 will be permitted entry unless accompanied by parent.
This is the fourth event on this year’s Ig Nobel Tour of the UK, for National Science & Engineering Week.

A call to help unexpected discoveries get discovered
Several well-known, much-respected scientists published this letter in The Guardian:
We need more scientific mavericks
“Science is the belief in the ignorance of experts,” said Richard Feynman in the 1960s. But times change….
[But now,] applicants’ proposals must convince their peers that they serve national policies and are the best possible uses of resources. [A large number of] major discoveries [that] challenged mainstream science and would probably be vetoed today. Nowadays, fields where understanding is poor are usually neglected because researchers must convince experts that working in them will be beneficial.
However, small changes would keep science healthy…. But policies are deeply ingrained. Agencies claiming to support blue-skies research use peer review, of course, discouraging open-ended inquiries and serious challenges to prevailing orthodoxies. Mavericks once played an essential role in research. Indeed, their work defined the 20th century. We must relearn how to support them, and provide new options for an unforeseeable future, both social and economic. We need influential allies. Perhaps Guardian readers could help?
NOTE: It has not escaped our notice that several of the scientists who wrote that letter have for a long time been encouraging and supporting things that make people LAUGH, then THINK.

Marc Abrahams's Blog
- Marc Abrahams's profile
- 14 followers
